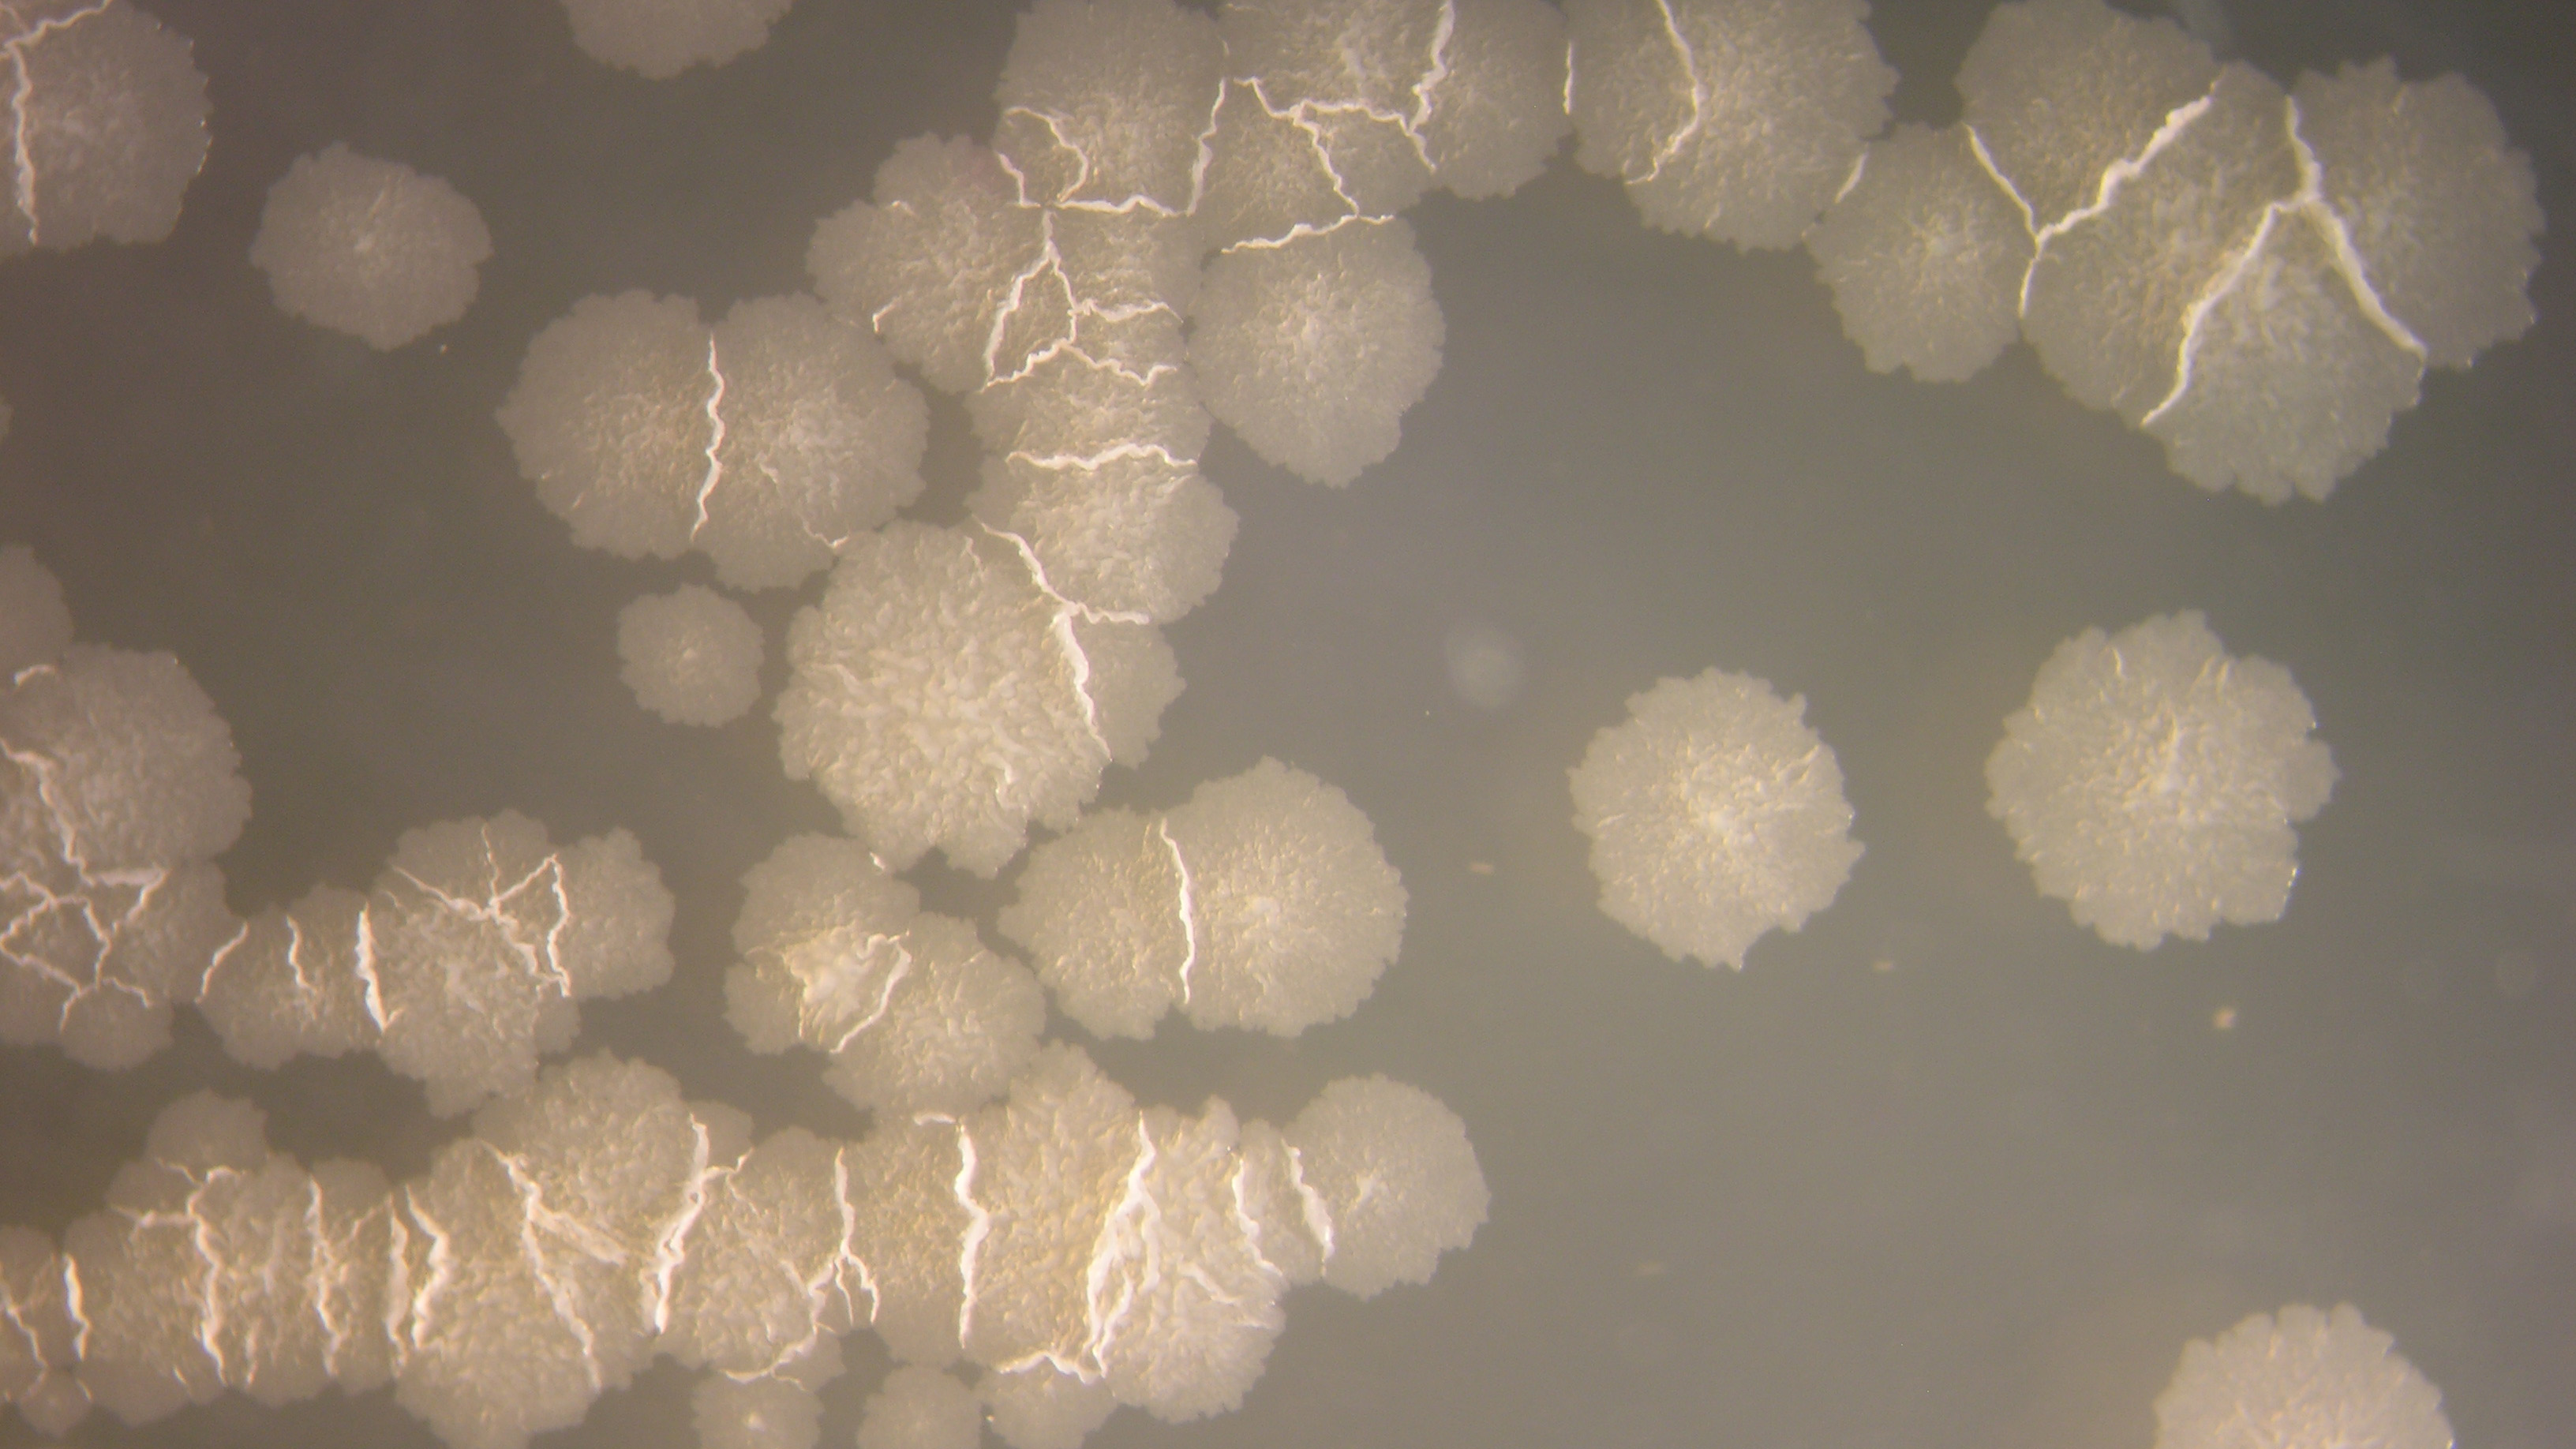

Krankheitserreger in der Lunge schneller nachweisen
- Tuberkulose-Bakterien wachsen nur sehr langsam und der Routine-Nachweis durch Bakterienkultur dauert mehrere Wochen. (Bild: IMM / UZH)
Mykobakterien verursachen verschiedene Krankheiten. Mycobacterium tuberculosis, der bedeutendste Vertreter dieser Gattung, ist der Erreger von Tuberkulose, an der 2014 weltweit rund 1,5 Millionen Menschen verstarben. Nicht-tuberkulöse Mykobakterien können bei geschwächtem Immunsystem Lungeninfektionen, Lymphknotenentzündungen und Hauterkrankungen auslösen. Solche schwer zu behandelnde Infektionen nahmen – bedingt durch immer mehr Menschen mit chronischen Lungenerkrankungen und den Erfolg der Transplantationsmedizin – in den letzten Jahrzehnten stetig zu.
Wenige Tage statt mehrere Wochen
Eine Forschungsgruppe des Instituts für Medizinische Mikrobiologie der Universität Zürich und des Nationalen Zentrums für Mykobakterien untersuchte in einer gross angelegten Studie mit mehr als 6800 Patientenproben molekulare Methoden zum Nachweis von krankmachenden Mykobakterien. Da viele Mykobakterien nur sehr langsam wachsen, nimmt der Routine-Nachweis durch Bakterienkultur in hoch spezialisierten, teuren Sicherheitslabors mehrere Wochen in Anspruch. Die anschliessende Empfindlichkeitsprüfung zur Bestimmung des geeigneten Medikaments benötigt ebenfalls ein bis zwei Wochen. «Für Patienten und Ärzte ist diese lange Wartezeit eine unnötige Geduldsprobe», sagt Dr. Peter Keller vom Institut für Medizinische Mikrobiologie der UZH. «Mit molekularen Nachweisverfahren wissen die meisten Patientinnen und Patienten dagegen bereits in ein bis zwei Tagen, ob eine Infektion mit Tuberkuloseerregern oder mit nicht-tuberkulösen Mykobakterien vorliegt.»
Für ihre Studie entwickelten die Forschenden einen diagnostischen Algorithmus, bei dem Mykobakterien mittels genetischer Analyse direkt aus der Patientenprobe nachgewiesen werden. Mit diesem ultraschnellen molekularen Nachweisverfahren wurden die Patientenproben über drei Jahre fortlaufend untersucht und mit den Ergebnissen aus den Bakterienkulturen bei mehr als 3000 Patienten verglichen. Es zeigte sich, dass die neuen molekularen Verfahren den bisherigen langwierigen kulturellen Untersuchungen ebenbürtig sind.
Resistenz gegenüber Standardmedikamenten testen
Zudem ist es mit der molekularen Analyse erstmals möglich, auch die nicht-tuberkulösen Mykobakterien innerhalb weniger Stunden direkt aus der Patientenprobe nachzuweisen. Somit können geeignete Therapiemassnahmen viel rascher eingeleitet werden. Liegt hingegen eine Tuberkuloseinfektion vor, wird eine weitere molekulare Untersuchung angeschlossen, um die Empfindlichkeit gegenüber den wichtigsten Tuberkulose-Medikamenten «Rifampicin» und «Isoniazid» zu testen. «Hier zeigte sich ebenfalls, dass das molekulare Verfahren die kulturellen Resistenzergebnisse zuverlässig vorhersagt. Es herrscht viel früher Gewissheit, ob die gewählte Therapie mit den Standartmedikamenten erfolgsversprechend ist», erklärt Keller.
Literatur:
Vanessa Deggim-Messmer, Guido V. Bloemberg, Claudia Ritter, Antje Voit, Rico Hömke, Peter M. Keller, Erik C. Böttger. Diagnostic molecular mycobacteriology in regions with low tuberculosis endemicity: combining real-time PCR assays for detection of multiple mycobacterial pathogens with line probe assays for identification of resistance mutations. EBioMedicine, 13. Juni 2016. DOI: http://dx.doi.org/10.1016/j.ebiom.2016.06.016. Link zum Artikel